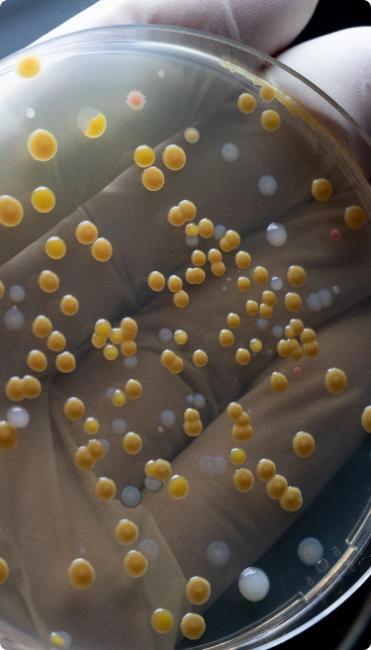
Mikroviologiko - Nitsos Lab

Σάββατο 8:00-12:00
-
Ευρύ φάσμα υπηρεσιών υψηλών προδιαγραφών και ελέγχου ποιότητας
-
Main contentΕυρύ φάσμα υπηρεσιών υψηλών προδιαγραφών και ελέγχου ποιότηταςΕυρύ φάσμα υπηρεσιών υψηλών προδιαγραφών και ελέγχου ποιότηταςΕυρύ φάσμα υπηρεσιών υψηλών προδιαγραφών και ελέγχου ποιότητας
Υπηρεσίες
Σύγχρονος τεχνολογικός εξοπλισμός και συνεχής ποιοτικός έλεγχος που εξασφαλίζουν την αξιοπιστία των αποτελεσμάτων αλλά και την ταχύτητα των αναλύσεων.

Δωρεάν προληπτικές εξετάσεις, για όλους τους πολίτες, εύκολα και γρήγορα, χωρίς ταλαιπωρία.
Η ΝΙΤΣΟΣ ΔΙΑΓΝΩΣΤΙΚΗ συμμετέχει στο πρόγραμμα, διενεργώντας τις εξετάσεις με αξιοπιστία και άμεση εξυπηρέτηση.
Με υπερσύγχρονες υποδομές, άρτια εξειδικευμένο προσωπικό και τελευταίας τεχνολογίας εξοπλισμό, διασφαλίζουμε την ακρίβεια των αποτελεσμάτων, ενώ η διαδικασία είναι απλή και χωρίς οικονομική επιβάρυνση για τους δικαιούχους με τα αποτελέσματα να δίδονται αυθημερόν.
Εθνικό πρόγραμμα ΠΡΟΛΑΜΒΑΝΩ proliptikes.gov.gr
Με το Εθνικό Πρόγραμμα για την Πρόληψη και Αντιμετώπιση Καρδιαγγειακών Κινδύνων, η Πολιτεία στοχεύει στην έγκαιρη ανίχνευση και διάγνωση επικίνδυνων καρδιαγγειακών επεισοδίων μέσω της αξιολόγησης βασικών παραγόντων κινδύνου.Το πρόγραμμα με την παροχή δωρεάν προληπτικών εργαστηριακών εξετάσεων απευθύνεται σε όλους τους πολίτες από 30 έως και 70 ετών που διαθέτουν ΑΜΚΑ, είτε είναι ασφαλισμένοι είτε ανασφάλιστοι.
Οι δωρεάν προληπτικές εργαστηριακές εξετάσεις περιλαμβάνουν:
- Ολική χοληστερόλη (TCHOL)
- Χοληστερόλη των χαμηλής πυκνότητας λιποπρωτεϊνών (LDL-C)
- Χοληστερόλη των υψηλής πυκνότητας λιποπρωτεϊνών (HDL-C)
- Τριγλυκερίδια (Tgs)
- Σάκχαρο αίματος – γλυκόζη (CL)
- Γενική Αίματος
- Προσδιορισμός λιποπρωτεϊνης α {LP (a)}.
Τμήματα-Εξετάσεις
Το μικροβιολογικό εργαστήριο διαθέτει τα εξής τμήματα:Αιματολογικό
Το θεμέλιο της κλινικής διάγνωσης
Ανοσολογικό
Το εργαλείο διερεύνησης, πορείας και διαχείρισης νόσου
Βιοχημικό
Υποστήριξη υγείας σε όλα τα στάδια
Ιολογικό
Ανίχνευση αντιγόνων και αντισωμάτων
Μικροβιολογικό
Εξετάσεις και καλλιέργειες βιολογικών υγρών
Ορμονολογικό
Εξετάσεις και κλινική εκτίμηση
Μοριακή Βιολογία - Γενετικές Εξετάσεις
Καινοτομία και Ποιότητα
Κυτταρολογικό
Επεξεργασία δειγμάτων υπό ασφαλείς συνθήκες
Υπερήχων
Απεικόνιση σε πραγματικό χρόνο

Η αξιοπιστία και η ταχύτητα των αποτελεσμάτων αποτελεί βασικό μας στόχο
Εξειδικευμένο ιατρικό προσωπικό και ποιοτικοί έλεγχοι διεθνών προτύπων.
Με την αξιοπιστία της Roche - Hitachi To νέο και υπερσύγχρονο “cobas pure e402 & c303” που εξοπλίστηκε το διαγνωστικό μας πρόσφατα είναι ένα από τα κορυφαία αναλυτικά συστήματα παγκοσμίως και…Τα αποτελέσματα βγαίνουν σε μία εργάσιμη ημέρα από την παραλαβή του δείγματος. Εφαρμόζεται μέθοδος υψηλής ευαισθησίας και ειδικότητας, εγκεκριμένη από τον Παγκόσμιο Οργανισμό Υγείας (WHO) με…